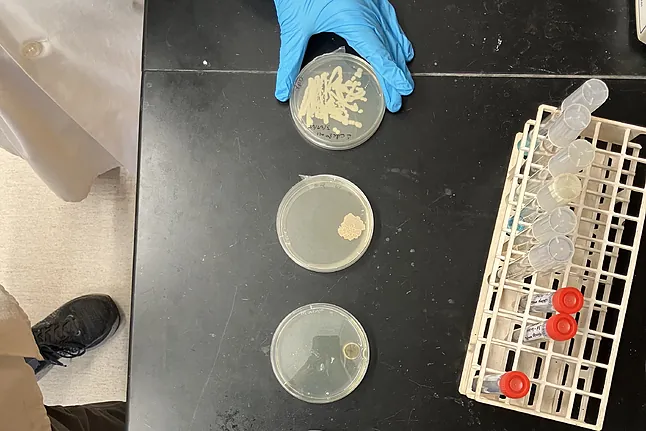
17439285486469 62793

Los zombis de The Last of Us se vuelven "realistas" para los científicos: "El calentamiento global está propagando hongos dañinos"
 Humano colonizado por el hongo Cordyceps en The last of us.HBO MAX
Humano colonizado por el hongo Cordyceps en The last of us.HBO MAX
Por: Ricardo F. Colmenero The Last of Us regresa el 13 de abril y, esta segunda temporada, de acuerdo con la ciencia, es "más realista" que nunca, y eso que estamos hablando de zombis. La historia, protagonizada por Pedro Pascal y Bella Ramsey, va sobre un mundo apocalíptico en el que la mayor parte de la humanidad ha sido infectada por el hongo Cordyceps, lo que los convierte en muertos vivientes.
Si vamos a la letra pequeña del asunto, lo primero es que el hongo Cordyceps es un parásito que tiene unas 400 especies, que existe en todo el mundo, especialmente en China, Corea, Japón y Tailandia, y que en los años 50 del siglo pasado sirvió para crear un antibiótico para la tuberculosis, y en los 80 para evitar el rechazo de órganos trasplantados.
En cuanto a lo de convertirnos en zombis parece que, de momento, sólo a algunos insectos, especialmente a las hormigas. Los hongos producen enzimas que degradan la pared del exoesqueleto, y perforan su cabeza, como si de repente le saliera una planta, y colonizan su cerebro y su voluntad, con el objetivo de que trepe a una rama alta para morir, y que su cuerpo, al pudrirse, esparza mucho mejor sus esporas por el bosque, y colonizar otros insectos.
De hecho, extrapolándonos con una hormiga, más que morder a otros, quizá si el Cordyceps se hiciera con nuestro cerebro nos impulsaría a irnos a morir a un rascacielos, para que nuestro cadáver pudiera expulsar esporas desde lo más alto de la ciudad.
"A los hongos les encanta producir esporas", afirma el Dr. Jim Kronstad, profesor y microbiólogo de los Laboratorios Michael Smith de la UBC (University of British Columbia), quien se ha puesto a estudiar la serie.
La ciencia aplaude que el Cordyceps, en esta segunda temporada, abunde en que la infección a los humanos se produzca liberando esporas en el aire, en lugar de a través de raíces, que parecían conectar a unos zombis con otros en la primera temporada. "Lo de las esporas a través del aire es algo más cercano a la realidad científica", explica Kronstad.
Placas con colonias de los hongos patógenos Ustilago maydis y Cryptococcus neoformans.Alex Walls
Placas con colonias de los hongos patógenos Ustilago maydis y Cryptococcus neoformans.Alex Walls
Durante los últimos mil millones de años, el reino fúngico se ha diversificado hasta alcanzar más de dos millones de especies, de las cuales más del 95% aún no se han descrito. Y les hemos ido encontrado un montón de aplicaciones, desde el pan con levadura a las bebidas alcohólicas y los biocombustibles, hasta productos farmacéuticos, incluyendo antibióticos y compuestos psicoactivos. También pueden utilizarse para fabricar materiales resistentes y ligeros, algunos de los cuales podrían usarse en el espacio.
"Son importantísimos y es fantástico lo que han hecho por los humanos", añade el Dr. Kronstad, destacando su capacidad para reciclar la materia orgánica muerta, y su papel como sumideros de carbono.
"El Cordyceps es inofensivo e incluso comestible, en la vida real", apunta Kronstad, como es en el caso de las hamburguesas veganas. Pero no es ciencia ficción que estemos investigando si podría volverse dañino, como en la serie, con motivo del calentamiento global.
Ahora mismo los hongos ya son responsables de decenas de enfermedades humanas, como la tiña o la candidiasis vaginal. El Cryptococcus neoformans, por ejemplo, causa meningitis en los humanos y, como el Cordyceps, también se propaga por inhalación de esporas.
En un artículo publicado el mes pasado en Nature, el Dr. Kronstad y coautores destacaban el calentamiento global como un posible contribuyente a la propagación de hongos dañinos. Y ponía ejemplos con nombre y apellidos, como el Coccidioides, que causa la fiebre del valle, o el Candida auris, que en estos momentos está infectando a pacientes hospitalizados y que, como se teme con el Cordyceps, es resistente a todos los medicamentos antimicóticos disponibles.
Los autores también destacaron el descubrimiento el año pasado en dos hospitales de china muy separados entre sí de un nuevo hongo, el Rhodosporidiobolus fluvialis, por primera vez en humanos, y que también es resistente de los antifúngicos habituales. Según los expertos que publicaron su hallazgo en la revista Nature Microbiology, este descubrimiento ha abierto una caja de Pandora de preocupantes posibilidades.
"Las infecciones fúngicas representan riesgos para los ecosistemas, desde los cultivos hasta la fauna silvestre y los seres humanos; y se deben, en parte, al desplazamiento de personas y animales, que podrían estar acelerándose con el cambio climático", concluye Kronstad.
Fuente: EL MUNDO

